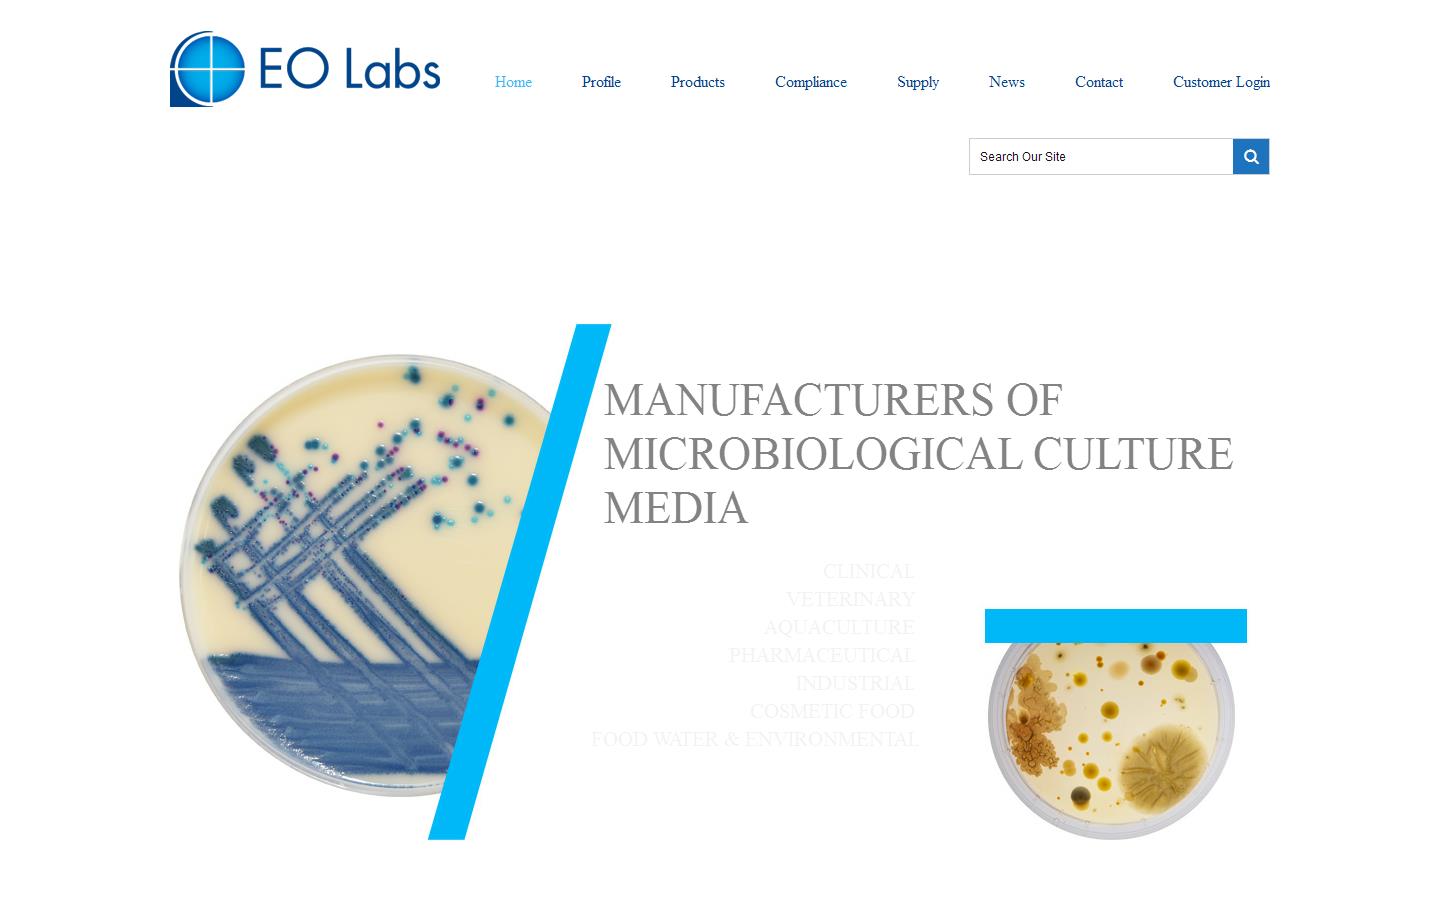

Company details for:
E & O Laboratories
(0)
Burnhouse Farm,
Bonnybridge,
Stirlingshire,
FK4 2HH,
United Kingdom
Quick Links:
About us
E&O Laboratories Ltd is the UK’s largest, and leading, privately owned, manufacturer of Culture Media. E&O supply a comprehensive, high quality product range in various formats and in a wide range of volumes and containers to satisfy all the different business sector’s compliance criteria and laboratory requirements.
E&O have two cGMP manufacturing sites to facilitate their fully automated production lines, steam sterilisation areas, validated clean-rooms and associated warehouse logistics function. Customer service, technical support, R&D, QC and QA are all sited at the main office in the Burnhouse facility.
All clinical products are CE marked, with industrial products being compliant with the Harmonized (USP/EP/JP) Pharmacopoeia standards.
E&O have two cGMP manufacturing sites to facilitate their fully automated production lines, steam sterilisation areas, validated clean-rooms and associated warehouse logistics function. Customer service, technical support, R&D, QC and QA are all sited at the main office in the Burnhouse facility.
All clinical products are CE marked, with industrial products being compliant with the Harmonized (USP/EP/JP) Pharmacopoeia standards.